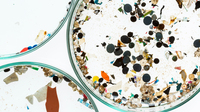

The Plastic in Our Clothing
The Plastic In Our Clothing
University of Porto, Portugal
Sarah at the Shopping Mall
Although she has many items of clothing already, she is looking for something she can wear both at work and during her free time.
Sarah has seen this material many times before but she is not familiar with what the material really is.
She tries on the trousers. She likes the way they look and feel. She decides to buy them and heads home.
Information About Polyester Fabric
What is Polyester?
It has been regularly used in clothing since around the 1960s.
Due to mass production of clothing and the growth of fast-fashion, polyester is a common material in both inexpensive and high-end clothing brands.
However, polyester is non-biodegradable and many studies have identified the negative health effects microplastics have on human and animal life.
Microplastics
Microplastics have even been found in human blood and can be damaging to human cells (Danopoulous, et al. 2020).
At Home
Sarah At Home
Washing Polyester Clothing
The amount of microfibers released depend on the fabric's construction.
According to a recent study conducted by the University of Plymouth and the National Research Council of Italy, 700 to 4,000 individual microfibres could be released during a single wash at 40'C (de Falco, et al. 2020).
Next Day
The Next Day
The restaurant is not far from where she lives.
The weather is nice, so she decides to walk there.
Releasing Microfibres During Regular Wear
According to a recent study, 400 fibres per gram of fabric could be shed by polyester items during just 20 minutes of normal activity (de Falco, et al. 2020).
A Full Closet
Sarah's Closet
She has a large closet full of blouses, skirts, and jackets that are all made out of these harmful materials.
Microfibres Shed Each Year
A Year Later
Sarah A Year Later
The cycle continues.
Consumer Habits and Health Concerns
Fast Fashion Contributes to Plastic Pollution
Learning More
UN Alliance for Sustainable Fashion
She is curious to learn more.
Sarah's Change in Habits
She is now purchasing less clothing and when she does, she makes more environmentally-friendly decisions.
She considers the fabric material and the longevity of the item.
Rethinking Her Wardrobe
She participates in clothing-swaps and finds quality clothes at second-hand shops.
She is happy knowing that her small changes can have a positive impact.
Resources for a Plastic Free Future
https://unfashionalliance.org/
Environmental Protection Agency
www.epa.gov/sites/default/files/2020-08/documents/article_2_microfibers_formatted.pdf
National Geographic
www.nationalgeographic.com/environment/article/plastic-pollution
UN Clean Seas
www.cleanseas.org/
References
De Falco, et al (2020) Microfiber Release to Water, Via Laundering, and to Air, via Everyday Use: A Comparison between Polyester Clothing with Differing Textile Parameters, Environ Sci Technol, 17;54(6):3288-3296.
Geyer et al (2022) Quantity and fate of synthetic microfiber emissions from apparel washing in California and strategies for their reduction, Environmental Pollution, 298.
Napper et al. (2020) The efficency of devices intended to reduce microfibre release during clothes washing' Science of The Total Environment, 738.
















































 The Plastic In Our Clothing
The Plastic In Our Clothing
 Sarah at the Shopping Mall
Sarah at the Shopping Mall

 What is Polyester?
What is Polyester?
 Polyester Jackets
Polyester Jackets
Microplastics
Microplastics
 Sarah At Home
Sarah At Home
 Washing Polyester Clothing
Washing Polyester Clothing
 The Next Day
The Next Day
 Releasing Microfibres During Regular Wear
Releasing Microfibres During Regular Wear
 Sarah's Closet
Sarah's Closet
 Microfibres Shed Each Year
Microfibres Shed Each Year

 Sarah A Year Later
Sarah A Year Later
 Consumer Habits and Health Concerns
Consumer Habits and Health Concerns
 Fast Fashion Contributes to Plastic Pollution
Fast Fashion Contributes to Plastic Pollution
 UN Alliance for Sustainable Fashion
UN Alliance for Sustainable Fashion
 Sky Report:Ocean Rescue
Sky Report:Ocean Rescue
 Sarah's Change in Habits
Sarah's Change in Habits
 Rethinking Her Wardrobe
Rethinking Her Wardrobe
 Resources for a Plastic Free Future
Resources for a Plastic Free Future
 References
References